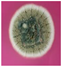
Coatings 13 01761 i058

Barrier and Antimicrobial Properties of Coatings Based on Xylan Derivatives and Chitosan for Food Packaging Papers
Abstract
:1. Introduction
2. Materials and Methods
2.1. Materials
2.2. Methods
- Obtaining xylan derivatives
- Preparation of xylan/xylan derivatives/chitosan colloidal dispersions
- Coating of papers
- Structural analysis of xylan derivatives by FT-IR
- Surface morphology by SEM
- Barrier properties
- Antimicrobial properties
3. Results and Discussion
3.1. Structural Analyses by FT-IR
3.2. Surface Morphology of Coated Papers
3.3. Barrier Properties
3.3.1. Air Permeability
3.3.2. Water Vapor Transmission Rate (WVTR)
3.3.3. Wettability and Water Absorptiveness
3.3.4. Grease and Oil Barrier
3.4. Antimicrobial Properties
4. Conclusions
Author Contributions
Funding
Institutional Review Board Statement
Informed Consent Statement
Data Availability Statement
Acknowledgments
Conflicts of Interest
References
- Herbes, C.; Beuthner, C.; Ramme, I. How green is your packaging—A comparative international study of cues consumers use to recognize environmentally friendly packaging. Int. J. Consum. Stud. 2020, 44, 258–271. [Google Scholar] [CrossRef]
- Testa, F.; Iovino, R.; Iraldo, F. The circular economy and consumer behaviour: The mediating role of information seeking in buying circular packaging. Bus. Strateg. Environ. 2020, 29, 3435–3448. [Google Scholar] [CrossRef]
- Doroudgarian, N. Nanocomposite Films of Hemicellulose and Nanocelluloses with Improved Barrier Properties for Packaging Applications. Master’s Thesis, Luleå University of Technology, Luleå, Sweden, November 2011. [Google Scholar]
- Ong, H.-T.; Samsudin, H.; Soto-Valdez, H. Migration of endocrine-disrupting chemicals into food from plastic packaging materials: An overview of chemical risk assessment, techniques to monitor migration, and international regulations. Crit. Rev. Food Sci. Nutr. 2022, 62, 957–979. [Google Scholar] [CrossRef]
- De Feo, G.; Ferrara, C.; Minichini, F. Comparison between the perceived and actual environmental sustainability of beverage packagings in glass, plastic, and aluminium. J. Clean. Prod. 2022, 333, 130158. [Google Scholar] [CrossRef]
- Mujtaba, M.; Lippone, J.; Ojanen, M.; Puttonen, S.; Vaittinen, H. Trends and challenges in the development of bio-based barrier coating materials for paper/cardboard food packaging; a review. Sci. Total Environ. 2022, 851, 158328. [Google Scholar] [CrossRef] [PubMed]
- Shen, M.; Huang, W.; Chen, M.; Song, B.; Zeng, G.; Zhang, Y. (Micro) plastic crisis: Unignorable contribution to global greenhouse gas emissions and climate change. J. Clean. Prod. 2020, 254, 120138. [Google Scholar] [CrossRef]
- Nechita, P.; Roman, M. Review on polysaccharides used in coatings for food packaging papers. Coatings 2020, 10, 566. [Google Scholar] [CrossRef]
- Reichert, C.L.; Bugnicourt, E.; Coltelli, M.-B.; Cinelli, P.; Lazzeri, A.; Canesi, I. Biobased packaging: Materials, modifications, industrial applications and sustainability. Polymers 2020, 12, 1558. [Google Scholar] [CrossRef]
- Mujtaba, M.; Morsi, R.E.; Kerch, G.; Elsabee, M.Z.; Kaya, M.; Labidi, J. Current advancements in chitosan-based film production for food technology; a review. Int. J. Biol. Macromol. 2019, 121, 889–904. [Google Scholar] [CrossRef]
- Helanto, K.; Matikainen, L.; Talja, R.; Rojas, O.J. Bio-based polymers for sustainable packaging and biobarriers. BioResources 2019, 14, 4902–4951. [Google Scholar] [CrossRef]
- Nešic, A.; Cabrera-Barjas, G.; Dimitrijevic-Brankovic, S.; Davidovic, S.; Radovanovic, N.; Delattre, C. Prospect of polysaccharide-based materials as advanced food packaging. Molecules 2020, 25, 135. [Google Scholar] [CrossRef] [PubMed]
- Saxenaa, A.; Elderb, T.J.; Ragauskasa, A.J. Moisture barrier properties of xylan composite films. Carbohydr. Polym. 2011, 84, 1371–1377. [Google Scholar] [CrossRef]
- Schnell, C.; Galván, M.; Peresin, M.; Inalbon, M.; Vartiainen, J.; Zanuttini, M.; Mocchiutti, P. Films from xylan/chitosan complexes: Preparation and characterization. Cellulose 2017, 24, 4393–4403. [Google Scholar] [CrossRef]
- Nechita, P.; Roman, M.; Năstac, S.M. Green Approaches on Modification of Xylan Hemicellulose to Enhance the Functional Properties for Food Packaging Materials—A Review. Polymers 2023, 15, 2088. [Google Scholar] [CrossRef] [PubMed]
- Zhong, L.X.; Peng, X.W.; Yang, D.; Cao, X.F.; Sun, R.C. Long chain anhydride modification: A new strategy for preparing xylan films. J. Agric. Food Chem. 2013, 61, 655–661. [Google Scholar] [CrossRef] [PubMed]
- Galván, M.V.; Peresin, M.S.; Mocchiutti, P.; Zanuttini, M.A.; Tammelin, T. Effects of charge ratios of xylan-poly(allylamine hydrochloride) complexes on their adsorption onto different surfaces. Cellulose 2015, 22, 2955–2970. [Google Scholar] [CrossRef]
- Nypelö, T.; Laine, C.; Colson, J.; Henniges, U.; Tammelin, T. Submicron hierarchy of cellulose nanofbril flms with etherifed hemicelluloses. Carbohydr. Polym. 2017, 177, 126–134. [Google Scholar] [CrossRef]
- Solier, Z.N.; Schnell, C.N.; Galván, M.V.; Mocchiutti, P.; Zanuttini, M.A.; Inalbon, M.C. Fast Preparation of Flexible Wet-Resistant and Biodegradable Films From a Stable Suspension of Xylan/Chitosan Polyelectrolyte Complexes. J. Polym. Environ. 2022, 30, 114–124. [Google Scholar] [CrossRef]
- Román-Doval, R.; Torres-Arellanes, S.P.; Tenorio-Barajas, A.Y.; Gómez-Sánchez, A.; Valencia-Lazcano, A.A. Chitosan: Properties and Its Application in Agriculture in Context of Molecular Weight. Polymers 2023, 15, 2867. [Google Scholar] [CrossRef]
- Popescu, P.-A.; Palade, L.M.; Nicolae, I.-C.; Popa, E.E.; Mitelut, A.C.; Draghici, M.C.; Matei, F.; Popa, M.E. Chitosan-Based Edible Coatings Containing Essential Oils to Preserve the Shelf Life and Postharvest Quality Parameters of Organic Strawberries and Apples during Cold Storage. Foods 2022, 11, 3317. [Google Scholar] [CrossRef]
- Bordenave, N.; Grelier, S.; Coma, V. Hydrophobization and antimicrobial activity of chitosan and paper-based packaging material. Biomacromolecules 2010, 11, 88–96. [Google Scholar] [CrossRef] [PubMed]
- Zhang, W.; Xiao, H.; Qian, L. Enhanced water vapour barrier and grease resistance of paper bilayer-coated with chitosan and beeswax. Carbohydr. Polym. 2014, 101, 401–406. [Google Scholar] [CrossRef] [PubMed]
- Mocchiutti, P.; Schnell, C.N.; Rossi, G.D.; Peresinb, M.S.; Zanuttini, M.A.; Galvána, M.V. Cationic and anionic polyelectrolyte complexes of xylan and chitosan. Interaction with lignocellulosic surfaces. Carbohydr. Polym. 2016, 150, 89–98. [Google Scholar] [CrossRef] [PubMed]
- Nechita, P.; Roman, M.; Cantaragiu Ceoromila, A.; Dediu Botezatu, A.V. Improving Barrier Properties of Xylan-Coated Food Packaging Papers with Alkyl Ketene Dimer. Sustainability 2022, 14, 16255. [Google Scholar] [CrossRef]
- ISO 5636-5:2013; Paper and Board, Determination of Air Permeance (Medium Range), Part 5: Gurley Method. International Organization for Standardization: Geneva, Switzerland, 2013.
- ISO 2528:2018; Sheet Materials, Determination of Water Vapours Transmission Rate (WVTR), Gravimetric (Dish) Method. International Organization for Standardization: Geneva, Switzerland, 2018.
- TAPPI T 458 cm-04; Surface Wettability of Paper (Angle of Contact Method). TAPPI Press: Atlanta, GA, USA, 2004.
- SR ISO 535: 2014; Paper and Board, Determination of Water Absorptiveness, Cobb Method. Romanian Association of Standardisation—ASRO: Bucharest, Romania, 2014.
- TAPPI T 441 om-09; Water Absorptiveness of Sized (Non-Bibulous) Paper, Paperboard, and Corrugated Fiberboard (Unger Cobb Test). TAPPI Press: Atlanta, GA, USA, 2009.
- T-559 cm-12; Grease Resistance Test for Paper and Paperboard. KIT Test. TAPPI Press: Atlanta, GA, USA, 2012.
- SR EN ISO846; Plastics—Evaluation of the Action of Microorganisms. Romanian Association of Standardisation—ASRO: Bucharest, Romania, 2000.
- ISO 846:2000; Evaluation of the Action of Microorganisms on Plastics. International Organization for Standardization: Geneva, Switzerland, 2000.
- Cheng, H.N.; Biswas, A.; Kim, S.; Alves, C.R.; Furtado, R.F. Synthesis and Characterization of Hydrophobically Modified Xylans. Polymers 2021, 13, 291. [Google Scholar] [CrossRef]
- Tanpichai, S.; Srimarut, Z.; Woraprayote, W.; Malila, Z. Chitosan coating for the preparation of multilayer coated paper for food-contact packaging: Wettability, mechanical properties, and overall migration. Int. J. Biol. Macromol. 2022, 213, 534–545. [Google Scholar] [CrossRef]
- Habibie, S.; Hamzah, M.; Anggaravidya, M.; Kalembang, E. The effect of chitosan on physical and mechanical properties of paper. J. Chem. Eng. Mater. Sci. 2016, 7, 1–10. [Google Scholar]
- Stepan, A.M. Bioplastics from Biomass—Acetylation of Xylans with Green Chemistry. Ph.D. Thesis, Chalmers University of Technology, Gothenburg, Sweden, 2013. [Google Scholar]
- Egüésa, I.; Stepan, A.M.; Eceizaa, A.; Toriz, G.; Gatenholm, P.; Labidia, J. Corncob arabinoxylan for new materials. Carbohydr. Polym. 2014, 102, 12–20. [Google Scholar] [CrossRef]
- Ham-Pichavant, F.; Sèbe, G.; Pardon, P.; Coma, V. Fat resistance properties of chitosan-based paper packaging for food applications. Carbohydr. Polym. 2005, 61, 259–265. [Google Scholar] [CrossRef]
- Kopacic, S.; Walzl, A.; Hirn, U.; Zankel, A.; Kniely, R.; Leitner, E.; Bauer, W. Application of industrially produced chitosan in the surface treatment of fibre-based material: Effect of drying method and number of coating layers on mechanical and barrier properties. Polymers 2018, 10, 1232. [Google Scholar] [CrossRef]
- Boonmahitthisud, A.; Booranapunpong, C.; Pattaradechakul, C.; Tanpichai, S. Development of water-resistant paper using chitosan and plant-based wax extracted from banana leaves. Int. J. Biol. Macromol. 2023, 15, 240:124412. [Google Scholar] [CrossRef]
- Piselli, A.; Garbagnoli, P.; Alfieri, I.; Lorenzi, A.; Del Curto, B. Natural-based coatings for food paper packaging. Int. J. Des. Sci. Technol. 2014, 20, 55–78. [Google Scholar]
- Grease Proof Paper. Available online: https://arrosi.com/en/products/greaseproof-paper/greaseproof-paper (accessed on 24 September 2023).
- Bobu, E.; Nicu, R.; Obrocea, P.; Ardelean, E.; Dunca, S.; Balaes, T. Antimicrobial properties of coatings based on chitosan derivatives for applications in sustainable paper, conservation. Cellul. Chem. Technol. 2016, 50, 689–699. [Google Scholar]
- Yang, Y.C.; Mei, X.W.; Hu, Y.J.; Su, L.Y.; Bian, J.; Li, M.F.; Peng, F.; Sun, R.C. Fabrication of antimicrobial composite films based on xylan frompulping process for food packaging. Int. J. Biol. Macromol. 2019, 134, 122–130. [Google Scholar] [CrossRef] [PubMed]
- Xu, G.; Luo, Y.; Song, T.; He, B.; Chang, M.; Ren, J. Preparation and application of a xylan-based antibacterial papermaking additive to protect against Escherichia coli bacteria. BioResources 2020, 15, 4781–4801. [Google Scholar] [CrossRef]
- Zakaria, S.; Chia, C.H.; Ahmad, W.H.W.; Kaco, H.; Chook, S.W.; Chan, C.H. Mechanical and Antibacterial Properties of Paper Coated with Chitosan. Sains Malays. 2015, 44, 905–911. [Google Scholar] [CrossRef]
- Fernandes, S.; Freire, C.S.; Pascoal Neto, C.; Gandini, A. The bulk oxypropilation of chitin and chitosan and the characterization of the ensuing polyols. Green Chem. 2008, 10, 93–97. [Google Scholar] [CrossRef]
- Fernández-Pan, I.; Maté, J.I.; Gardrat, C.; Coma, V. Effect of chitosan molecular weight on the antimicrobial activity and release rate of carvacrol-enriched films. Food Hydrocoll. 2015, 51, 60–68. [Google Scholar] [CrossRef]
- Ergene, C.; Palermo, E.F. Antimicrobial Synthetic Polymers: An Update on Structure-Activity Relationships. Curr. Pharm. Des. 2018, 24, 855–865. [Google Scholar] [CrossRef]













| Sample Codification | Xylan, % | AKD Hydrophobized Xylan, % | Acetylated Xylan, % | Chitosan, % |
|---|---|---|---|---|
| P0 (base paper) | - | - | - | - |
| Homogenous coatings—single layer—5 g/m2 | ||||
| P1 | 100 | - | - | - |
| P2 | - | 100 | - | - |
| P3 | - | - | 100 | - |
| P4 | 75 | - | - | 25 |
| P5 | - | 75 | - | 25 |
| P6 | - | - | 75 | 25 |
| P7 | 50 | - | - | 50 |
| P8 | - | 50 | - | 50 |
| P9 | - | - | 50 | 50 |
| P10 | - | - | - | 100 |
| Composite coatings—2 layers—5 g/m2 | ||||
| P11 | 100 (bottom layer) | - | - | 100 (top layer) |
| P12 | - | 100 (bottom layer) | - | 100 (top layer) |
| P13 | - | - | 100 (bottom layer) | 100 (top layer) |
| Paper Sample | Percentage of Fungal Growth Inhibition(%)/Assessment Method | |||||||
|---|---|---|---|---|---|---|---|---|
| Spraying | Flooding | |||||||
| 3 Days | 7 Days | 14 Days | 21 Days | 3 Days | 7 Days | 14 Days | 21 Days | |
| P0 | 1.00 | 0 | 0 | 0 | 0 | 0 | 0 | 0 |
| P1 | 2.00 | 0 | 0 | 0 | 0 | 0 | 0 | 0 |
| P2 | 0 | 0 | 0 | 0 | 0 | 0 | 0 | 0 |
| P3 | 2.5 | 1.2 | 0 | 0 | 0 | 0 | 0 | 0 |
| P7 | 65.00 | 0 | 0 | 0 | 95.00 | 55.00 | 39.00 | 0 |
![]() | ![]() | ![]() | ![]() | ![]() | ![]() | ![]() | ![]() | |
| P8 | 25.00 | 0 | 0 | 0 | 95.00 | 63.00 | 63.00 | 0 |
![]() | ![]() | ![]() | ![]() | ![]() | ![]() | ![]() | ![]() | |
| P9 | 21.12 | 0 | 0 | 0 | 95.00 | 40.00 | 23.00 | 0 |
![]() | ![]() | ![]() | ![]() | ![]() | ![]() | ![]() | ![]() | |
| P10 | 100.00 | 10.00 | 0 | 0 | 100.00 | 95.10 | 95.10 | 0 |
![]() | ![]() | ![]() | ![]() | ![]() | ![]() | ![]() | ![]() | |
| P12 | 50.00 | 0 | 0 | 0 | 100.00 | 90.00 | 90.00 | 0 |
![]() | ![]() | ![]() | ![]() | ![]() | ![]() | ![]() | ![]() | |
| P13 | 90.10 | 0 | 0 | 0 | 100.00 | 90.00 | 90.00 | 0 |
![]() | ![]() | ![]() | ![]() | ![]() | ![]() | ![]() | ![]() | |
| Paper Sample | Percentage of Fungal Growth Inhibition(%)/Assessment Method | |||||||
|---|---|---|---|---|---|---|---|---|
| Spraying | Flooding | |||||||
| 3 Days | 7 Days | 14 Days | 21 Days | 3 Days | 7 Days | 14 Days | 21 Days | |
| P0 | 1.00 | 0 | 0 | 0 | 0 | 0 | 0 | 0 |
| P1 | 0 | 0 | 0 | 0 | 2.4 | 1.2 | 0 | 0 |
| P2 | 0 | 0 | 0 | 0 | 1.5 | 0 | 0 | 0 |
| P3 | 0 | 0 | 0 | 0 | 3.4 | 2.6 | 1.7 | 0 |
| P7 | 95.00 | 42.00 | 31.15 | 31.15 | 35.00 | 1.00 | 1.00 | 1.00 |
![]() | ![]() | ![]() | ![]() | ![]() | ![]() | ![]() | ![]() | |
| P8 | 51.00 | 0 | 0 | 0 | 40.00 | 0 | 0 | 0 |
![]() | ![]() | ![]() | ![]() | ![]() | ![]() | ![]() | ![]() | |
| P9 | 65.12 | 0 | 0 | 0 | 30.00 | 1.00 | 1.00 | 1.00 |
![]() | ![]() | ![]() | ![]() | ![]() | ![]() | ![]() | ![]() | |
| P10 | 100.00 | 91.50 | 0 | 0 | 100.00 | 35.00 | 35.00 | 35.00 |
![]() | ![]() | ![]() | ![]() | ![]() | ![]() | ![]() | ![]() | |
| P12 | 100.00 | 100.00 | 100.00 | 100.00 | 95.00 | 35.00 | 35.00 | 35.00 |
![]() | ![]() | ![]() | ![]() | ![]() | ![]() | ![]() | ![]() | |
| P13 | 99.99 | 1.00 | 0 | 0 | 95.00 | 30.00 | 30.00 | 30.00 |
![]() | ![]() | ![]() | ![]() | ![]() | ![]() | ![]() | ![]() | |
Disclaimer/Publisher’s Note: The statements, opinions and data contained in all publications are solely those of the individual author(s) and contributor(s) and not of MDPI and/or the editor(s). MDPI and/or the editor(s) disclaim responsibility for any injury to people or property resulting from any ideas, methods, instructions or products referred to in the content. |
© 2023 by the authors. Licensee MDPI, Basel, Switzerland. This article is an open access article distributed under the terms and conditions of the Creative Commons Attribution (CC BY) license (https://creativecommons.org/licenses/by/4.0/).
Share and Cite
Roman, M.; Nechita, P.; Vasile, M.-A.; Cantaragiu Ceoromila, A.-M. Barrier and Antimicrobial Properties of Coatings Based on Xylan Derivatives and Chitosan for Food Packaging Papers. Coatings 2023, 13, 1761. https://doi.org/10.3390/coatings13101761
Roman M, Nechita P, Vasile M-A, Cantaragiu Ceoromila A-M. Barrier and Antimicrobial Properties of Coatings Based on Xylan Derivatives and Chitosan for Food Packaging Papers. Coatings. 2023; 13(10):1761. https://doi.org/10.3390/coatings13101761
Chicago/Turabian StyleRoman (Iana-Roman), Mirela, Petronela Nechita, Mihaela-Aida Vasile, and Alina-Mihaela Cantaragiu Ceoromila. 2023. "Barrier and Antimicrobial Properties of Coatings Based on Xylan Derivatives and Chitosan for Food Packaging Papers" Coatings 13, no. 10: 1761. https://doi.org/10.3390/coatings13101761
APA StyleRoman, M., Nechita, P., Vasile, M.-A., & Cantaragiu Ceoromila, A.-M. (2023). Barrier and Antimicrobial Properties of Coatings Based on Xylan Derivatives and Chitosan for Food Packaging Papers. Coatings, 13(10), 1761. https://doi.org/10.3390/coatings13101761